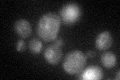
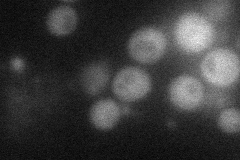

View description
Protein of unknown function, required for viability in rich media of cells lacking mitochondrial DNA; mutants have an invasive growth defect with elongated morphology; induced by amino acid starvation
Localization:
Intensity:
Fold change:
Significance:
-
C’ GFP library in SD
vacuole membrane34.6 -
N' NOP1pr-GFP in SD
cytosol38.9249 -
N' TEF2pr-mCherry in SD

below threshold5.93525 -
N' NATIVEpr-GFP in SD

cytosol24.2174 -
N' TEF2pr-VC and Cyto-VN in SD

#N/A0 -
C’ GFP library in SD+DTT

vacuole membrane20.060.57Yes -
C’ GFP library in SD+H2O2

vacuole membrane24.450.7No -
C’ GFP library in Starvation Media

vacuole membrane22.440.64Yes -
C’ GFP library on the background of Pup2-DaMP

vacuole membrane -
C’ GFP library on the background of CCT mutant

vacuole membrane25.97610.750638No
